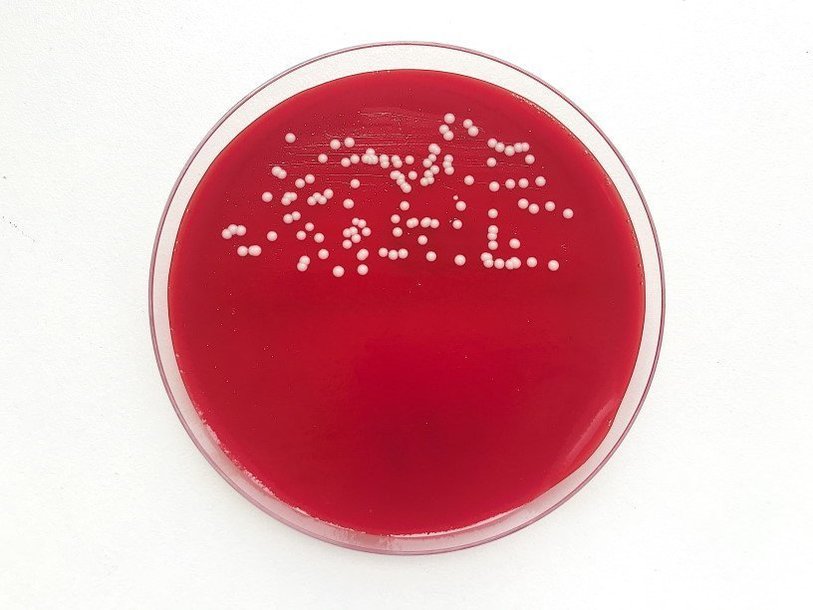

Екатерина Беленко: Промикробы: Все салаты подъедены
Фото: Екатерина Беленко
Фото: Екатерина Беленко Надеюсь, что вы все оклемались от праздника лени и целенькими и здоровенькими вошли в рабочий режим. Может показаться, что я напрасно за вас переживаю, но на самом деле новогодний стол несет множество микробиологических опасностей. Начнем с самого банального — с оливье, хорошенько заправленного сметанно-майонезным питательным субстратом. Обычно его готовят в промышленных масштабах, потом он всю ночь стоит на теплом столе, хорошо если на балкон вынесут хоть ненадолго. Просто идеальные условия для счастливой жизни и размножения бактерий. Поэтому не надо жадничать, готовьте меньше или хотя бы не заправляйте сразу весь тазик.
⠀
Хоть на дворе и зима, но на большинстве праздничных столов, думаю, были свежие овощи и зелень. Если вы забыли их помыть, то в складках аппетитного зелененького салатного листа вас может радостно поджидать кишечная палочка. И вроде такая же точно живет у вас в кишечнике и пользу приносит, но чуть другая кишечная палочка вполне может вместо пользы принести вред. Но я не призываю вас к излишней чистоплотности, сама с удовольствием ем немытые фрукты. Риск — мое второе имя.
⠀
А еще в детстве бабушка очень любила пугать меня сальмонеллезом. А вас? Главную опасность по мнению бабушки, представляли яйца, поэтому их надо было всегда в достаточной мере термически обрабатывать. А потом я выросла и в университете как раз сальмонеллу изучала. Тогда я узнала, что куриные яйца — не самая любимая среда обитания сальмонелл. Они любят яйца водоплавающих птиц, к которым курица совсем не относится. А яйца диких уток вы вряд ли часто едите. Еще в процессе написания диплома я выискивала сальмонеллу в воде из реки Дон, а потом заражала ею лабораторных мышей, но это уже совсем другая история.
⠀
Я на этих праздниках с трудом могла переносить социальные сети: огромное количество моих друзей поехали в Европу и выкладывали дразнящие фотографии. Вот они точно поели и бри, и камамбер, и дорблю. Спасибо плесени за это. Самый главный и незаменимый элемент новогоднего застолья появляется на свет благодаря микробиологическим знаниям и умениям. Я, конечно, про шампанское, создание которого невозможно без дрожжей. Но если вам плохо от шампанского, то это не из-за дрожжей или микробов, не пытайтесь на них спихнуть.
Смотрите также: Екатерина Беленко Промикробы: Ода кишечной микрофлоре Екатерина Беленко Промикробы: Грибы большие и маленькие Екатерина Беленко Промикробы: моча, окутанная мифами Александра Брутер Меню выбирает бактерия